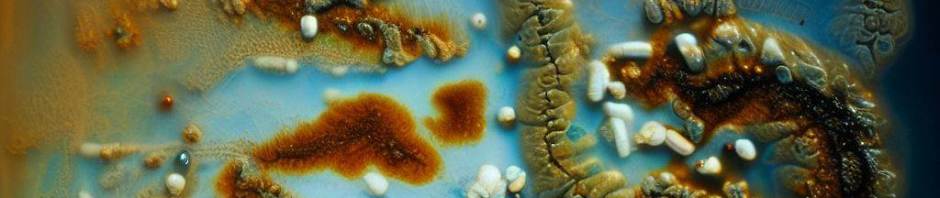

Do you have recurring infections such as Candida, Mold, Lyme? Have you had the same infections return time after time even though you did the proper protocol? The underlying issue may be Biofilms.

Biofilms in the gut are complex communities of microorganisms, including bacteria, fungi, and other microbes, that adhere to the surface of the intestinal lining and form a protective matrix known as a biofilm.
Biofilms in the gut can have both positive and negative effects. On the positive side, they contribute to the development of a healthy gut microbiota by providing a protective environment for beneficial bacteria. They can also help maintain the integrity of the intestinal barrier and modulate immune responses.
What are biofilms?
Biofilms are extracellular matrices that surround and protect the microbes inside from immune system detection. As part of this system, these organisms use quorum sensing (a communication system used by microbes) to assemble a matrix of extracellular polymeric substances. This slimy matrix surrounds and adheres to the organisms inside. Because biofilms are highly resistant to antimicrobials and antibiotics, the microbes inside go undetected and are challenging to address.
Sometimes Biofilms and interfere with natural and pharmaceutical treatments. Biofilms have been associated with Candida overgrowth, Lyme disease and mold-related illnesses. These conditions involve the formation of biofilms by the infecting organism which can contribute to chronic or recurring infections and make treatment more challenging.
In the case of Candida overgrowth, Candida species can form biofilms in various parts of the body, including the gut. Candida biofilms are often resistant to conventional antifungal treatments, which makes them difficult to eradicate. These biofilms can contribute to persistent or recurrent Candida infections and may be associated with symptoms such as digestive issues, fatigue, and immune dysfunction.
One of the organisms in Lyme disease, Borrelia burgdorferi transmitted through tick bites, can also form biofilms. These biofilms allow the bacteria to evade the immune system and antibiotics, leading to chronic Lyme disease. These biofilms may contribute to the persistence of symptoms even after standard antibiotic treatments.
Mold-related illnesses, such as those caused by certain species of mold, can also involve biofilm formation. Mold biofilms can be found in damp outdoor environments or within the respiratory system. Biofilms provide a protective environment for mold, making it more resistant to cleaning and remediation efforts, and contribute to respiratory symptoms and allergic reactions in susceptible individuals.
Here are some ways biofilms help protect offending organisms and minimize treatment protocols or the body’s immune system:
- Physical Barrier: The biofilm matrix creates a physical barrier that shields the microorganisms within it. This barrier helps protect them from mechanical removal, such as through the body’s immune responses or physical cleaning methods.
- Antibiotic Resistance: Biofilms have been found to exhibit higher resistance to antimicrobial agents, including antibiotics.
- Nutrient Availability: The biofilm acts as a barrier that restricts the penetration of antibiotics, making it difficult for the medications to reach and eliminate the microorganisms within the biofilm. The biofilm can trap and concentrate essential nutrients, providing a continuous supply to the microorganisms within the biofilm. This promotes survival and growth of microorganisms like mold, Lyme bacteria and Candida.
- Cooperative Interactions: Microorganisms within the biofilms can engage in cooperative interactions, which can further enhance their survival and resistance. Some microorganisms in biofilm may produce substance that protect others from external threats or enhance their ability to resist treatments.
These protective mechanisms allow mold, Lyme bacteria, and Candida to persist, evade the immune system, and resist conventional treatments. Disrupting or dissolving biofilms can help overcome these protective barriers and improve the effectiveness of antimicrobial therapies. However, targeting biofilms can be challenging due to their complex structure and resistance mechanisms.
Before dissolving Biofilms, each person must evaluate what steps are needed to prepare the body before attacking the biofilms. Digestion, elimination, detox pathways all need to be working and supported before treatment begins. Working with a knowledgeable practitioner is necessary for good outcomes.
After the proper preparation has been done, BioDisrupt® has been very helpful. BioDisrupt® is a clinically researched formula with two proprietary blends. EnzymeDisrupt and HerbDisrupt. These blends work synergistically to provide microbial biofilm support by disrupting the biofilm matrix and inhibiting the formation of new biofilms.
BioDisrupt® supports the healthy immune system’s ability to target the sophisticated self-defense mechanisms of biofilms.
How does BioDisrupt® offer support?

BioDisrupt® is a clinically researched formula with two proprietary blends: EnzymeDisrupt™ and HerbDisrupt™. These blends work synergistically to provide comprehensive microbial biofilm support by disrupting the biofilm matrix and inhibiting the formation of new biofilms.*
EnzymeDisrupt™ is a blend of unique enzymes specifically chosen for their researched ability to disrupt the biofilm matrix. Disrupting this matrix exposes the microbes inside, allowing the immune system to do its job more effectively. *
HerbDisrupt™ is a unique blend of herbs chosen for their researched ability to support the natural anti-adhesion properties, making it more difficult for biofilms to adhere within the body and interrupting the microbes’ ability to communicate through quorum-sensing. *
Mechanisms of Action*
- Disrupt biofilm matrices*
- Interrupt quorum-sensing (biofilm intra/intercommunication)*
- Support the body’s anti-adhesion properties*
| Features | Constituents/Actions | Benefits* |
| EnzymeDisrupt™ | Lysozyme, Serratiopeptidase, Beta-glucanase, Lipase, Protease 4.5, Cellulase, Hemicellulase | • Enzymes promoting the body’s normal ability to disrupt extracellular matrices |
| HerbDisrupt™ | Cranberry (fruit) extract, Berberine, Rosemary (aerial) extract, Peppermint oil powder | • Clinically researched herbs to support the body’s normal anti-adhesion properties and promote digestive comfort • Microbial support nutrients to promote the body’s healthy response to invading organisms • Nutrients to promote healthy level of extracellular mucus • Herbs to promote healthy microbe colony communication |
Dosage: 2 capsules twice per day between meals, at least 2 hours after eating or 1 hour before eating. (Do not use if pregnant or nursing)
Click here to order.